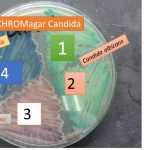
Chromagar Candida
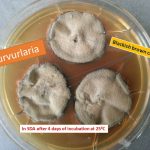
Curvurlaria

Collection Group: Mycology
Germ Tube Test (GTT) for Candida: Introduction, Principle, Procedure, Result and Interpretation
 Introduction of Germ Tube Test This procedure is used for...
Introduction of Germ Tube Test This procedure is used for...
CHROMagar Candida: Use, Composition, Preparation, Colony Morphology, Result and Interpretation
Use of CHROMagar Candida CHROMagar Candida or HiCrome candida differential...
Use of CHROMagar Candida CHROMagar Candida or HiCrome candida differential...
Curvularia: Introduction, Morphology, Pathogenicity, Laboratory Diagnosis and Treatment
Introduction of Curvularia/Cochliobolus Curvularia lunata is even being a fungal plant pathogen that...
Introduction of Curvularia/Cochliobolus Curvularia lunata is even being a fungal plant pathogen that...
